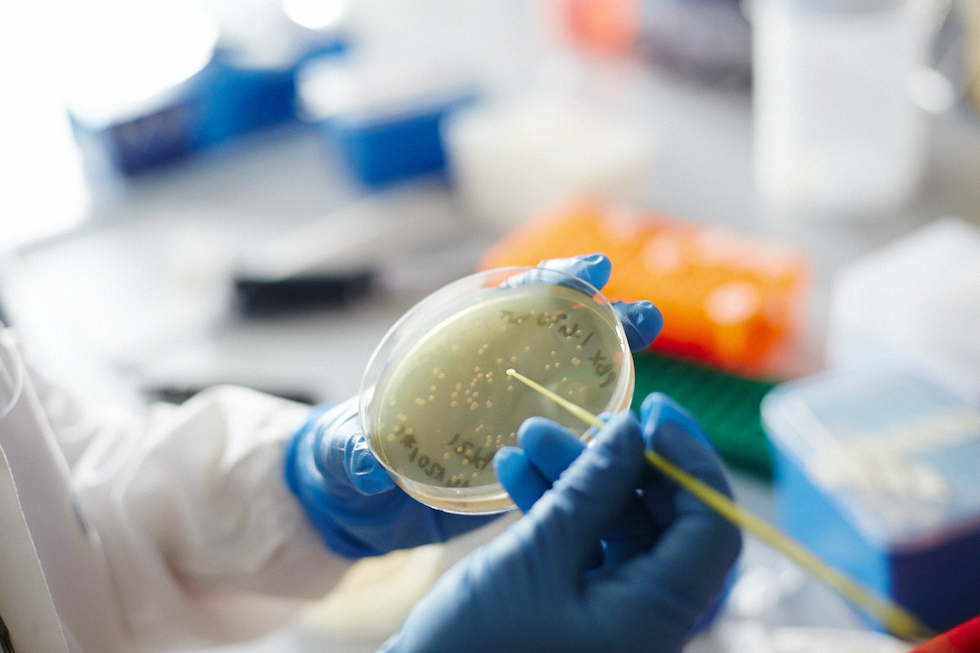

Senza ricerca di base non c’è ricerca
Nemmeno in medicina: lo dimostra la storia di un batterio scoperto nei geyser dello Yellowstone

In ambito medico-scientifico, la ricerca di base studia il funzionamento delle cellule e degli organismi. Ha l’obiettivo di scoprire i principî di come funzionano le cose e grazie al suo lavoro si ottengono le conoscenze necessarie e indispensabili a svolgere tutte le fasi successive della ricerca: quelle che hanno come risultato ultimo terapie e farmaci.
Per questi motivi, la ricerca di base è senza dubbio fondamentale, ma è anche meno in vista, e rischia di ricevere minori attenzioni. «Per uno che lavora sui meccanismi di base del funzionamento delle cellule, per esempio la replicazione del DNA, e magari lo sta facendo in un lievito, è dura far capire che sta facendo qualcosa di importante per il cancro», dice il professor Pier Paolo Di Fiore, ricercatore AIRC – la fondazione per la ricerca sul cancro –, docente di Patologia generale all’università di Milano e oncologo molecolare dello IEO, l’Istituto Europeo di Oncologia. Senza capire i meccanismi di base della replicazione del DNA, però, non si potrebbero nemmeno iniziare a comprendere i meccanismi alla base dei tumori, continua Di Fiore, che è anche autore del libro Il prezzo dell’immortalità, dedicato allo studio dei tumori, vincitore nel 2021 del Premio Galileo per la divulgazione scientifica.
La ricerca medica è divisa sostanzialmente in tre fasi. La prima è appunto la ricerca di base, anche detta “fondamentale”: quella che si fa in laboratorio e che ha come obiettivo la conoscenza dei meccanismi che regolano i processi biologici. Una volta che si è acquisita una certa conoscenza in un campo, si può cercare di trasformarla in un’applicazione pratica: è quello che fa la ricerca traslazionale, che verifica la possibilità di utilizzare le scoperte scientifiche della ricerca di base in applicazioni cliniche.
La terza fase è quella della ricerca applicata, che ha il compito di trasformare dei prototipi di ricerca in qualcosa di concreto: e quindi farmaci, test diagnostici, procedure interventistiche, terapie. Per ottenerli bisogna combinare i risultati di tre momenti distinti della ricerca applicata.
Il primo in ordine temporale è la cosiddetta ricerca preclinica, che deve verificare l’efficacia e la sicurezza di una nuova cura in modelli sperimentali, per esempio sugli animali. Solo a questo punto si può passare alla sperimentazione sugli umani, cioè alla ricerca clinica, che valuta quali effetti collaterali produce un trattamento e ne registra i risultati, portandolo eventualmente all’approvazione. Poi c’è la ricerca epidemiologica, che effettua studi sulla popolazione per capire la distribuzione di una malattia e cosa la causa.
La complessità di questo lungo percorso fa sì che la ricerca di base sia più lontana dal paziente e, per questo, la sua importanza è più difficile da spiegare: è un fattore che può diventare molto problematico quando si parla di finanziamenti.
Anche per questo è fondamentale la presenza di organizzazioni specializzate e con una visione di lungo periodo come AIRC, la fondazione per la ricerca sul cancro, che fa dei finanziamenti alla ricerca di base uno dei propri impegni principali. L’obiettivo di AIRC – trovare cure contro il cancro – non sarebbe infatti possibile se la ricerca non venisse continuamente alimentata alla fonte, finanziando appunto la ricerca di base.
AIRC è una fondazione che raccoglie i propri fondi dal contributo volontario, anche minimo, di milioni di persone. Per il 2022 AIRC ha potuto destinare alla ricerca sul cancro 136 milioni di euro a partire da 4,5 milioni di donatori che la sostengono nelle iniziative e negli eventi in tutta Italia, attraverso il 5 per mille o grazie alle donazioni che chiunque può fare online.
Può capitare che gli impulsi a studiare una cosa al livello della ricerca di base arrivino da osservazioni cliniche, e quindi con obiettivi più tangibili, ma la ricerca di base comincia soprattutto dalla curiosità di una ricercatrice o un ricercatore verso qualcosa che ritiene interessante. Il problema, come spiega il professor Di Fiore, è comunicare all’esterno che una cosa “interessante” può essere anche “importante” e utile: «A priori non possiamo sapere se una cosa è importante, possiamo solo studiarla. Poi alcune delle cose che studiamo funzionano, ma prima non lo possiamo sapere». È l’approccio alla base del metodo scientifico, come spiega Di Fiore attraverso un episodio particolare: come da un batterio si è arrivati alla PCR, che oggi è applicata in diversi ambiti ed è uno dei principali metodi diagnostici usati in medicina.
A metà degli anni Settanta, alcuni scienziati dell’università di Cincinnati si posero il problema di capire come fosse possibile che un batterio, chiamato Thermus aquaticus e scoperto alcuni anni prima, fosse capace di vivere a temperature altissime, fino a 80 gradi, nei geyser del parco nazionale di Yellowstone, negli Stati Uniti. Questi ricercatori scoprirono che una peculiarità interessante di questo batterio era il fatto che la sua DNA polimerasi, un enzima che serve a duplicare il DNA, riuscisse a svolgere le proprie funzioni a quelle temperature. Quell’enzima venne rinominato Taq polimerasi. Era interessante, ma non era chiaro in che modo quella scoperta potesse diventare importante e utile.
Alcuni anni più tardi, negli anni Ottanta, venne inventata una tecnica biochimica per analizzare il DNA chiamata PCR (sigla inglese che sta per “reazione a catena della polimerasi”), che si basava sull’utilizzo di una DNA polimerasi. L’invenzione era notevole, ma inizialmente aveva il difetto che molte DNA polimerasi non resistono alle temperature necessarie al processo della PCR (oltre i 90 gradi): sarebbe servita a poco se non fosse stato possibile perfezionarla grazie all’uso della Taq polimerasi, che era stata scoperta anni prima per la curiosità apparentemente poco “utile” di alcuni gruppi di ricerca.
«La PCR ha rivoluzionato la medicina», fa notare Di Fiore. È una tecnica che molti hanno sentito nominare negli ultimi due anni, perché è quella usata per la rilevazione del coronavirus nei tamponi molecolari. «È chiaro che è difficile avere statistiche, ma con la PCR negli ultimi vent’anni ci saranno state decine di milioni di vite influenzate, salvate, migliorate», dice Di Fiore.
Più di recente, nel 2017, i tre ricercatori statunitensi Jeffrey C. Hall, Michael Rosbash e Michael W. Young hanno vinto il premio Nobel per la medicina per le loro scoperte sui “ritmi circadiani”, l’orologio interno degli esseri viventi. I loro studi hanno spiegato come le piante, gli esseri umani e gli altri animali adattano i ritmi biologici per essere sincronizzati con un giorno solare: tra le altre cose, il loro lavoro è stato fondamentale per capire la causa di alcuni tumori e come massimizzare l’efficacia di alcuni farmaci somministrandoli in determinati orari. Tutto però era cominciato tra gli anni Settanta e Ottanta, dall’osservazione del corredo genetico dei moscerini della frutta.
La storia della scienza dimostra continuamente che senza conoscenza non si possono trovare soluzioni. D’altra parte, spiega sorridendo Di Fiore, «senza conoscenza noi saremmo veramente degli animali piuttosto scarsi».
Tra i vari oggetti dei suoi studi, il professore si sta occupando di capire i meccanismi tramite i quali le cellule staminali adulte, che sono le uniche in grado di ripopolare gli organi, possono diventare cellule staminali del cancro, che sono fondamentalmente quelle che lo alimentano: «Capendo questi meccanismi potremmo anche cercare di capire come è possibile colpire selettivamente le cellule staminali del cancro per sterilizzare il tumore».
L’efficacia della ricerca sul cancro in tutte le sue fasi, a partire da quella di base, è dimostrata da un dato, spiega Di Fiore: negli ultimi 20 anni c’è stato ogni anno l’1,5 per cento di mortalità in meno a causa dei tumori, significa circa il 30 per cento in più di guarigioni rispetto a 20 anni fa. «Oggi noi curiamo poco più della metà dei tumori», conclude Di Fiore, «se mantenessimo il miglioramento dell’1,5 per cento all’anno, tra altri vent’anni potremo essere ragionevolmente all’80 per cento di guarigioni. All’inizio del Novecento si guariva da un tumore solo nel 4 per cento dei casi».